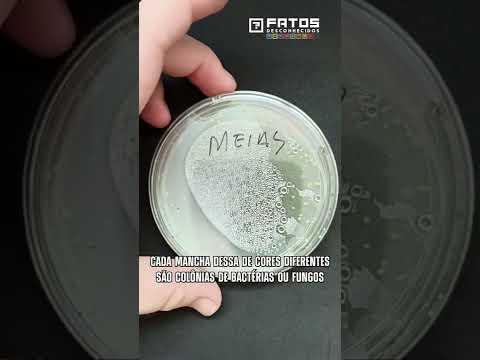

Na plateia, as histórias do público: Cristiane relembra do susto que levou ao ver seu marido entrando no motel. E Celso, conta o que aconteceu quando tentou arrumar um emprego nos Estados Unidos. #PorchatNoGNT #HistóriasDaPlateia nscreva-se no canal GNT: http://bit.ly/canalGNT Assista aos programas na íntegra no Globoplay + Canais: http://bit.ly/GloboplayCanaisGNT Site: https://gnt.globo.com/ Facebook: https://www.facebook.com/gnt Instagram:… Continuar lendo Histórias da Plateia: flagra no motel e primeiro emprego | Que História é essa, Porchat?
Blog em Vídeos
Nicolas Latifi bate em muro no GP da Arábia Saudita
Nicolas Latifi bate em muro e provoca Safety Car precisa entrar.
Leclerc e Verstappen brigam pela liderança no GP da Arábia Saudita
NO CAPRICHO, NO CAPRICHO! Uma disputa linda pela liderança entre Leclerc, da Ferrari, e Verstappen, da Red Bull.
Max Verstappen vence o GP da Arábia Saudita
RECEBA! Max Verstappen, da Red Bull, vence o GP da Arábia Saudita!
SHOW DO ESPORTE – 3ª EDIÇÃO – 27/03/2022 – PROGRAMA COMPLETO
Confira as melhores reportagens, entrevistas, palpites e análises do #ShowDoEsporte. Tudo comandado, é claro, por Glenda Kozlowski e Elia Junior. Siga o #ShowDoEsporte nas redes sociais: Instagram: https://www.instagram.com/showdoesporte/ Facebook: https://www.facebook.com/showdoesportenaband Twitter: https://twitter.com/showdoesporte
“Vítor Pereira errou ao tirar Paulinho e Willian”, diz Alex Muller
Alex Muller acredita que termômetro de Majestoso, foi quando Vítor Pereira, treinador do Corinthians, tira Paulinho e Willian. #TerceiroTempo #EsportenaBand #Corinthians
Quem é a esposa de Will Smith? A história de Jada Pinkett Smith
A premiação do Oscar sempre atrai os holofotes e é tema de discussão para muita gente. Mas, neste ano, o evento deu o que falar, quando o comediante Chris Rock foi estapeado, durante sua apresentação. Essa súbita agressão aconteceu depois de uma piada de mau gosto sobre a esposa do ator premiado, Will Smith. Nesse… Continuar lendo Quem é a esposa de Will Smith? A história de Jada Pinkett Smith
Quantas bactérias tem em nossas meias e sapatos? #Shorts
#Shorts
Operação contra golpes financeiros prende ao menos 14 pessoas em SP
Uma operação contra golpes financeiros prendeu ao menos 14 pessoas em São Paulo. Criminosos usavam um falso aplicativo de banco para ludibriar idosos do Rio Grande do Sul. Inscreva-se no canal Hoje em Dia: http://r7.com/DUqw Assista às íntegras no PlayPlus: https://www.playplus.com Facebook: https://www.facebook.com/ProgramaHojeEmDia/ Instagram: https://www.instagram.com/hojeemdia/ Twitter: https://twitter.com/hojeemdia Site oficial: https://recordtv.r7.com/hoje-em-dia #HojeEmDia
Caixa libera empréstimo para pessoas e empreendedores com nome sujo
A Caixa Econômica Federal liberou empréstimo para quem está com o nome sujo. Empreendedores e pessoas físicas poderão quitar o débito em até 24 meses. Inscreva-se no canal Hoje em Dia: http://r7.com/DUqw Assista às íntegras no PlayPlus: https://www.playplus.com Facebook: https://www.facebook.com/ProgramaHojeEmDia/ Instagram: https://www.instagram.com/hojeemdia/ Twitter: https://twitter.com/hojeemdia Site oficial: https://recordtv.r7.com/hoje-em-dia #HojeEmDia